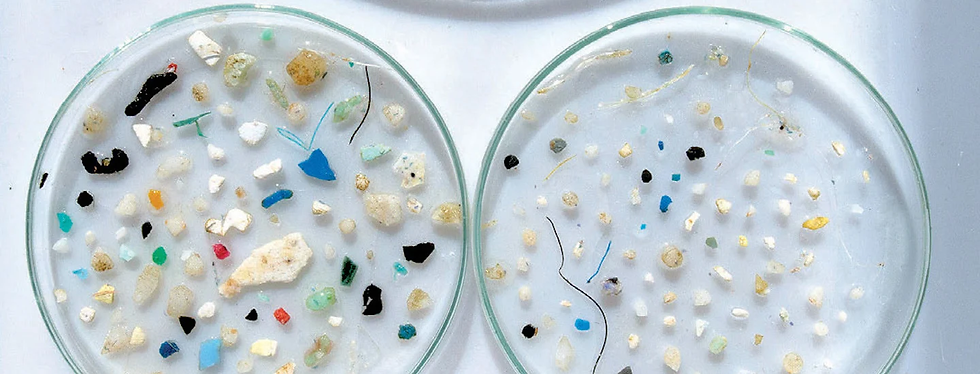
ree

Microplastics: They Are Everywhere
- Sena Aslıhan
- Dec 18, 2023
- 3 min read
Microplastics: one of the recent problems of the world and humanity. They are found in nearly everywhere that human beings have access to, from marine environments to remote locations like the Arctic. Moreover, Japanese scientists have recently made a surprising discovery that there are microplastics in the clouds as well.
But what are microplastics? Microplastics are tiny pieces of plastics that are smaller than five millimeters which are considered as pollutants. They are usually results of breakdown of larger plastics or commercial product development and categorized as primary and secondary. Primary microplastics are results of personal product usage, and come from cosmetic goods and microfibers whereas secondary microplastics are particles of larger plastics. The most common ones are synthetic polymers which are, polyethylene, polypropylene, polystyrene, polyamide, polyester and acrylic.
Microplastics have been detected nearly everywhere around the world from the Mariana Trench to Mount Everest, and also in marine organisms, seafood and even drinking water and human organs, it is hard to find somewhere sacred from humanity's polluting activities to the environment. The existence of polymer and microplastics in drinking water poses a greater threat since the companies can not remove them completely, even though the threat it possesses to human health still stays unknown. Only in the oceans, the amount of microplastics pollution has reached 14 million tons yearly. Additionally, it is commonly believed that if the trend goes on there will be more plastics in the ocean than fish by weight, by the year of 2050. But, how? The direct release of litter to the oceans, loss of industrial material, fishing activities and atmospheric particle shedding are several reasons behind the water pollution microplastics contribute to.
The main reason behind microplastics being pollutants is that it takes hundreds of years to decompose in the environment, since they are not biodegradable. Furthermore, it is even suggested that all the plastics that have been released to the environment still exist. Them being a pollutant and having negative effects on the wildlife and also human health have resulted in several countries taking action to reduce the usage and decrease the drawbacks. Such as, Canada considering microplastics, and specifically microbeads, as toxic substances; British Columbia lowering the usage and number of single-use plastics; President Barack Obama signing The Microbead-Free Waters Act of 2015 into law.
Let’s talk about the discovery that the Japanese scientists from the Waseda University made. The 44 samples that were taken from the mist peak and foot of Mount Fuji and the peak of Mount Oyama, Fuji being the highest mountain of Japan, showed that there were microplastics in the clouds and the sky as well. Researchers have found equal to as much as 14 pieces in one liter of water having the size ranging from 7 to 95 micrometers, identifying polymers in nine different kinds and even rubber. The reason behind is believed to be the sea sprays that form clouds. A professor from the Waseda University, Hiroshi Okochi suggests that “Microplastics in the free troposphere are transported and contribute to global pollution.” Even though little is knew about the effects of the microplastics in the clouds it is predicted that it will have damages on the environment thoroughly via contributing to climate change, causing irreversible harm to animals and farm corps via returning to the ground as a particle in a rain droplet, making it harder to find clean water and generally clean sources due to pollution.
All in all, not only companies and countries but also individuals have to take action in order to prevent the effects of microplastics getting worse before it is too late. And yes, you can also do something on this severe issue! Individuals can take action to stop microplastic pollution by dropping the usage of single-use plastics, recycling, doing research on the topic, choosing public transportation over private transportation and reducing the usage of synthetic fabrics. Else, it will become one of the biggest problems that humanity has ever faced.
Works Cited:
National Geographic. “Microplastics | National Geographic Society.” Education.nationalgeographic.org, National Geographic, 20 May 2022, education.nationalgeographic.org/resource/microplastics/. Accessed 3 Dec. 2023.
Microplastics – Pollution Tracker. pollutiontracker.org/contaminants/microplastics/#:~:text=Microplastics are found globally in. Accessed 3 Dec. 2023.
“Blue Wonder.” Undp, feature.undp.org/blue-wonder/?gad_source=1&gcli d=CjwKCAiA04arBhAkEiwAuNOsIm5m-ftr9QRBCUlCkDQNcmy4OIcSQXbG6_C14tn3g_cEsJVAUrRH-xoCyQkQAvD_BwE. Accessed 3 Dec. 2023.
kallipso. “How to Stop Microplastic Pollution - 8 Tips.” Plastic Expert, 4 Jan. 2023, www.plasticexpert.co.uk/how-to-stop-microplastic-pollution/#:~:te xt=and%20plastic%20pollution%3A-. Accessed 4 Dec. 2023.
Rogers, Kara. “Microplastics.” Encyclopædia Britannica, 22 Apr. 2019, www.britannica.com/technology/microplastic. Accessed 4 Dec. 2023.
“Scientists Find Microplastics in the Clouds above Mount Fuji.” Yale E360, e360.yale.edu/digest/clouds-microplastics-climate. Accessed 4 Dec. 2023.
Media, Thred. “Japanese Scientists Find Microplastics in Earth’s Clouds.” Medium, 2 Oct. 2023, thredmedia.medium.com/japanese-scientists-find-m icroplastics-in-earths-clouds-ea57a7543db9. Accessed 4 Dec. 2023.
Microplastics Found in Clouds | Healthnews, healthnews.com/news/scientists- from-japan-discover-microplastics-in-clouds/. Accessed 4 Dec. 2023.
“Scientists Find Microplastics inside Clouds.” Futurism, futurism.com/the -byte/scientists-find-microplastics-inside-clouds. Accessed 5 Dec. 2023.